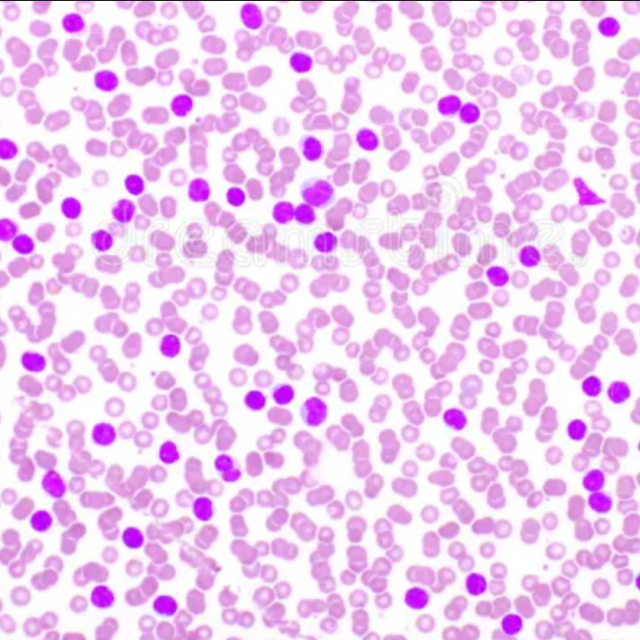

EMG Prosthetic Arm
Equipped with a motorized whisk mechanism for all your mixing needs.
I'm an Engineering Student at the University of Waterloo passionate about building hardware and software. Check out some of my favourite projects!

Equipped with a motorized whisk mechanism for all your mixing needs.

Automating the manipulation and navigation of catheters for medical professionals.

Pick up litter without lifting a finger.

Create your personalized Spotify listening history collage in seconds.
Detect and count all the white blood cells in a sea of red blood cells with one simple click.

Keep track of your collection safely and securely.